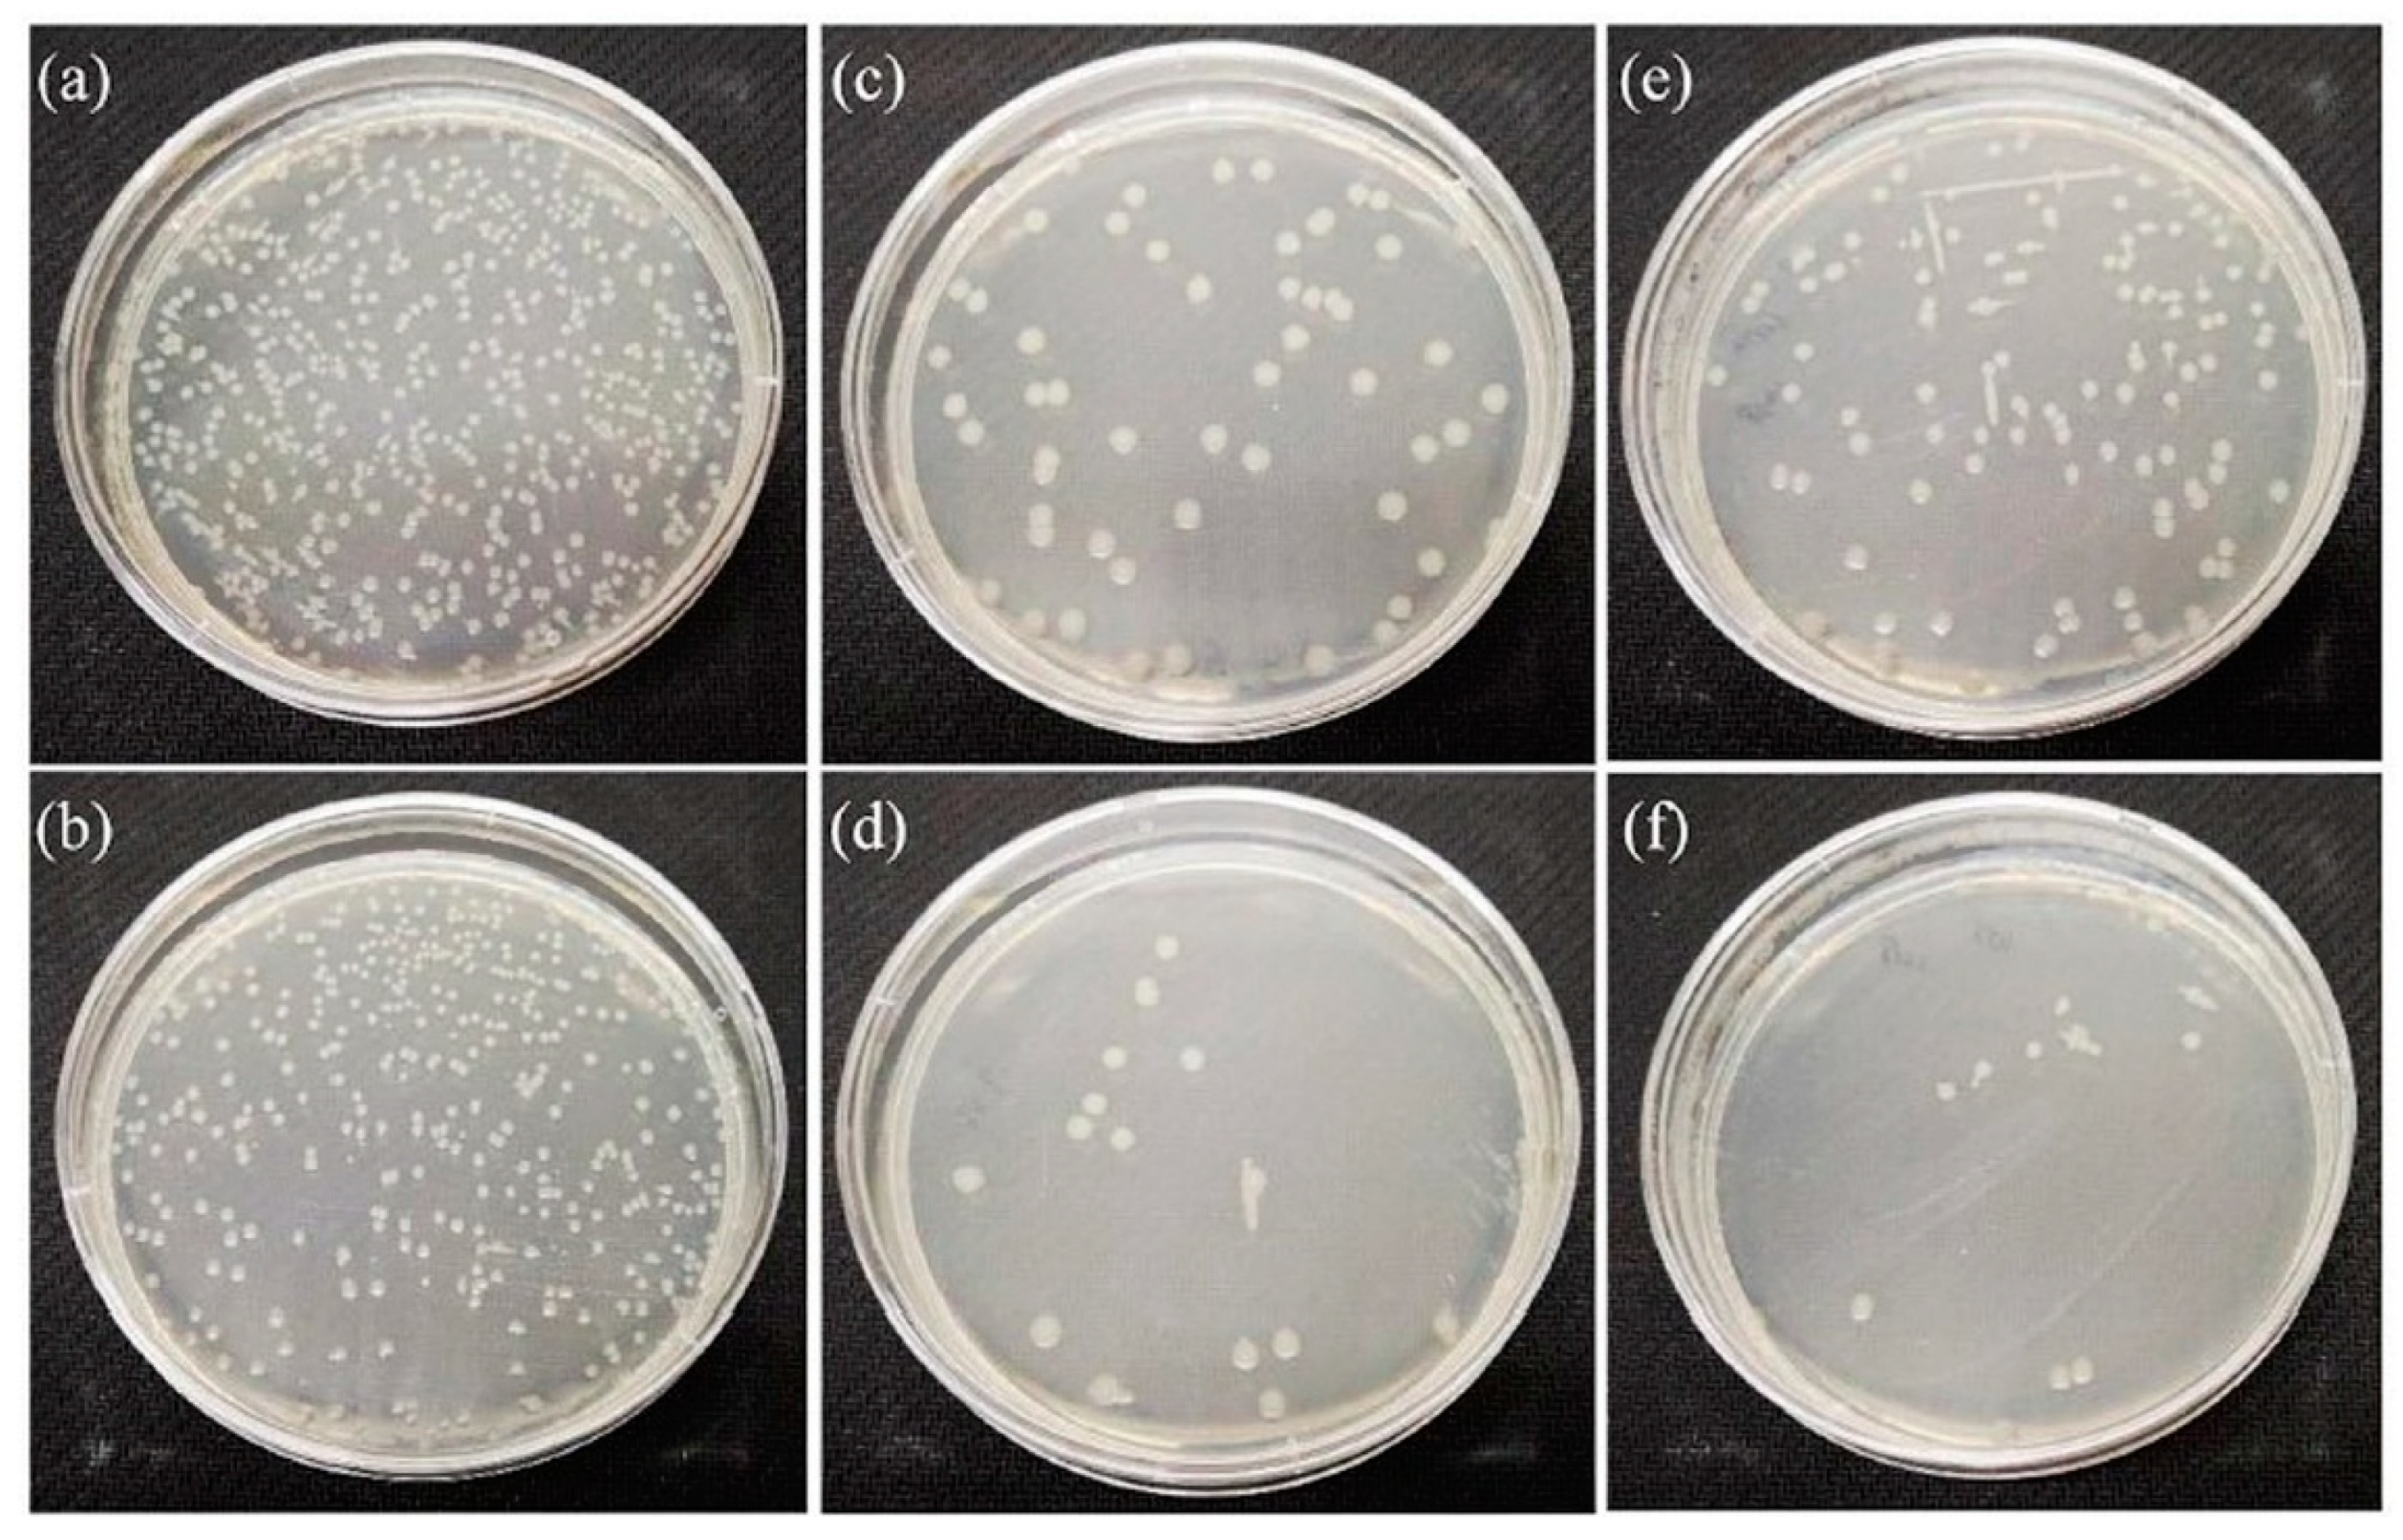
Applsci 15 04553 g013
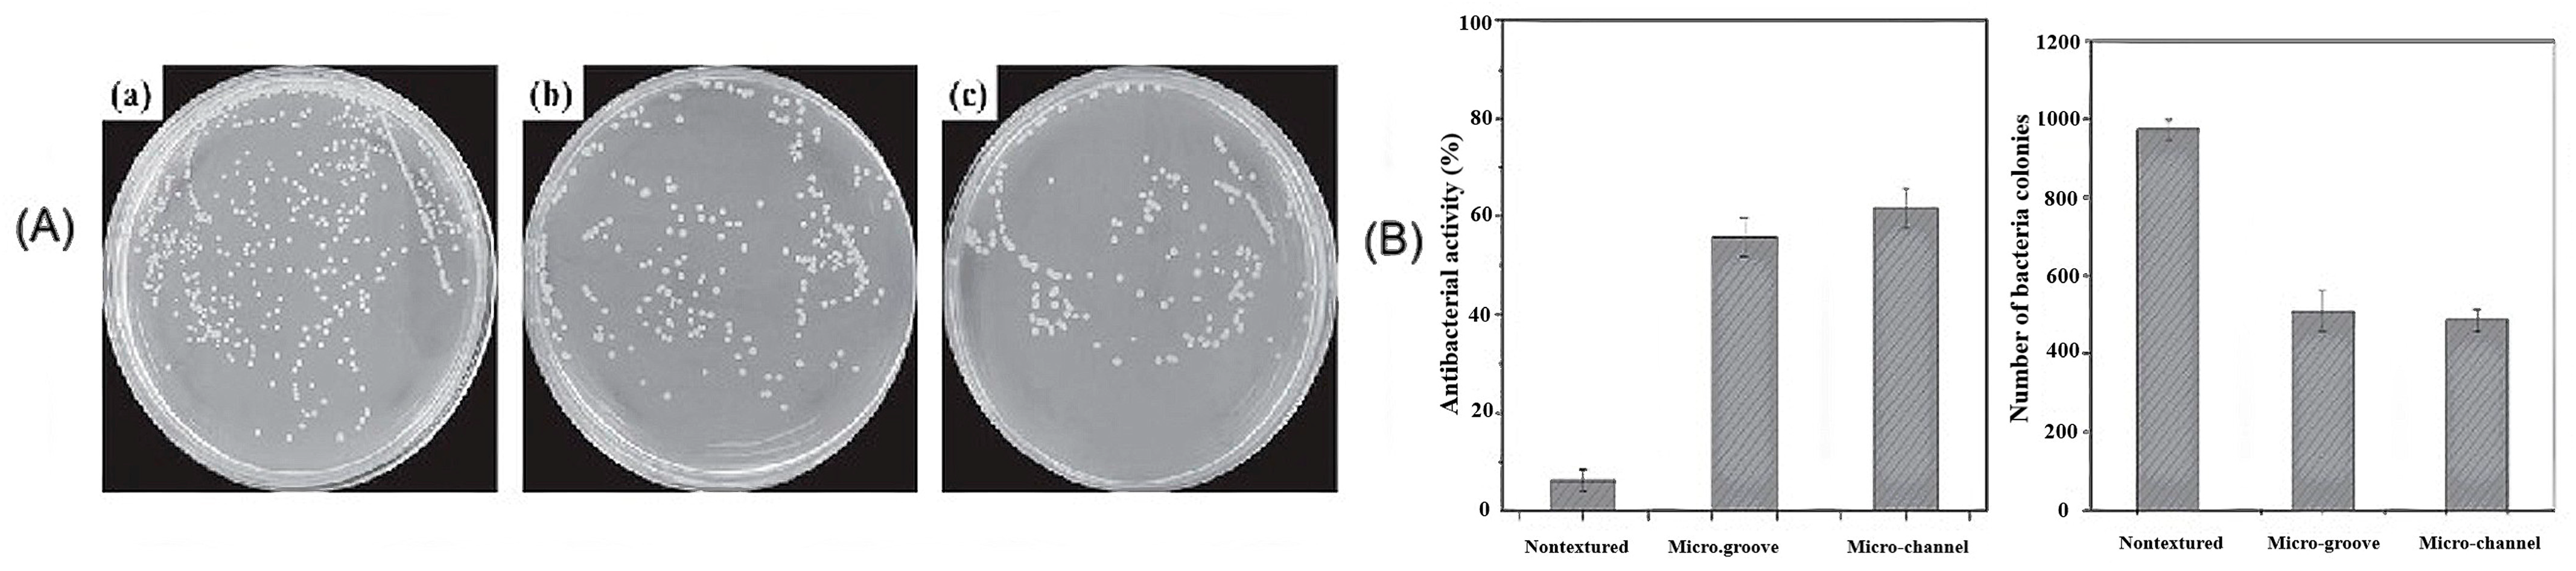
Applsci 15 04553 g016

Antibacterial Ceramics for Dental Applications
Abstract
1. Introduction
2. Materials and Methods
2.1. Protocols
2.2. Electronic Searches
2.3. Screening Process
2.4. Eligibility
3. Results and Discussion
3.1. Antibacterial Properties of Silver and Silver Ions
3.2. Antibacterial Properties of Cu and Cu Ions
3.3. Antibacterial Properties of Zinc Oxide
3.4. Antibacterial Properties of Strontium
3.5. Influence of Surface Properties on the Antibacterial Activity of Bioceramics
3.6. Antibacterial Activity of Cerium Oxide
4. Conclusions
Author Contributions
Funding
Conflicts of Interest
References
- Kowalska, K.J.; Czechowska, J.P.; Yousef, E.S.; Zima, A. Novel phosphate bioglasses and bioglas.s-ceramics for bone regeneration. J. Ceram. Inter. 2024, 50, 45976–45985. [Google Scholar] [CrossRef]
- Moeini, A.; Chinijani, T.H.; Khachatourian, A.M.; Fook, M.V.L.; Baino, F.; Montazerian, M. A critical review of bioactive glasses and glass-ceramics in cancer therapy. Int. J. Appl. Glass. Sci. 2023, 14, 69–87. [Google Scholar] [CrossRef]
- Homaeigohar, S.; Li, M.; Boccaccini, A.R. Bioactive glass-based fibrous wound dressings. J. Burn. Trauma 2022, 10, tkac038. [Google Scholar] [CrossRef] [PubMed]
- Zheng, K.; Niu, W.; Lei, B.; Bccaccini, A.R. Immunomodulatory bioactive glass for tissue regeneration. J. Acta Biomater. 2021, 133, 168–186. [Google Scholar] [CrossRef]
- Fu, L.; Engqvist, H.; Xia, W. Glass-ceramics in dentistry: A review. J. Mater. 2020, 13, 1049. [Google Scholar] [CrossRef] [PubMed]
- Yaday, A.K.; Tripathi, H.; Dubey, A.K.; Rath, C. In-vitro assessment of biocompatibility and antimicrobial properties of 85S bio-glass and SiTiO3 composites. J. Mater. Chem. Phys. 2024, 320, 129442. [Google Scholar]
- Silva, G.L.; Rodrigues, I.F.; Pereira, S.S.S.; Fontoura, G.M.G.; Reis, A.S.; Pedrochi, F.; Steimacher, A. Bioactive antibacterial borate glass and glass-ceramics. J. Non-Cryst. Solids 2022, 595, 121829. [Google Scholar] [CrossRef]
- Stipniece, L.; Skandis, I.; Mosina, M. Silver- and/or titanium-doped ß-tricalcium phosphate bioceramic with antibacterial activity against Staphylococcus aureus. J. Ceram Inter. 2022, 48, 10195–10201. [Google Scholar] [CrossRef]
- Zheng, K.; Bider, F.; Monavari, M.; Xu, Z.; Janko, C.; Alexiou, C.; Beltran, A.M.; Boccaccini, A.R. Sol-gel derived B2O3-CaO borate bioactive glasses with hemostatic, antibacterial and pro-angiogenic activities. J. Regener. Biomater. 2024, 11, rbad105. [Google Scholar] [CrossRef]
- Majumdar, S.; Hira, S.K.; Tripathi, H.; Kumar, A.S.; Manna, P.P.; Singh, S.P.; Krishnamurthy, S. Synthesis and characterization of barium-doped bioactive glass with potential anti-inflammatory activity. J. Ceram Inter. 2021, 47, 7143–7158. [Google Scholar] [CrossRef]
- Naresh, P.; Narsimlu, N.; Srinivas, C.; Shareefuddin, M.; Kumar, K.S. Ag2O doped bioactive glasses: An investigation on the antibacterial, optical, structural and impedance studies. J. Non-Crys. Solids 2020, 549, 120361. [Google Scholar] [CrossRef]
- ISO 6872:2024; Dentistry–Ceramic Materials. International Organization for Standardization: Geneva, Switzerland, 2024.
- Baptista, I.O.; Alves, M.F.R.P.; Ferreira, S.; Santos, C.; Vieira, S.I.; Fernandes, M.H.V. Antibacterial activity improvement of dental glass-ceramic by incorporation of AgVO3 nanoparticles. J. Dent. Mater. 2022, 38, 1679–1688. [Google Scholar] [CrossRef] [PubMed]
- Wie, Y.; Dang, G.; Ren, Z.; Wan, M.; Wang, C.; Li, H.; Zhang, T.; Tay, F.R.; Niu, L. Recent advances in the pathogenesis and prevention strategies of dental calculus. J. Npj Biofilms Microbiomes 2024, 10, 56. [Google Scholar]
- Yin, I.X.; Zhang, J.; Zhao, I.S.; Mei, M.L.; Li, Q.; Chu, C.H. The antibacterial mechanism of silber nanoparticles and its application in dentistry. Int. J. Nanomed. 2020, 15, 2555–2562. [Google Scholar] [CrossRef]
- Zhang, H.; Yu, H.; Jiang, S.; Dong, H.; Yan, C.; Liu, H.; Li, Q.; Jiang, H. Effect of different removal methods of excess resin adhesive on the microleakage of alumina all-ceramic crowns. BMC Oral Health 2023, 23, 854. [Google Scholar] [CrossRef]
- Xiao, C.F.R.; Zhang, Z.; Li, Y.; Yu, P.; Wang, Z.; Ning, C.; Deng, C.; Zhou, Z.; Wang, X.; Tan, G. Sodium aluminum silicate composite ceramics with secondary caries prevention for dental crown restoration. J. Mater. Lett. 2022, 325, 132805. [Google Scholar] [CrossRef]
- Ramburrun, P.; Pringle, N.A.; Dube, A.; Adam, R.Z.; D’Souza, S.; Aucamp, M. Recent advances in the development of antimicrobial and antifouling biocompatible materials for dental applications. J. Mater. 2021, 14, 3167. [Google Scholar] [CrossRef]
- Guo, W.; Dong, H.; Wang, X. Emerging roles of hydrogel in promoting periodontal tissue regeneration and repairing bone defect. J. Front. Bioengin. Biotech. 2024, 12, 1380528. [Google Scholar] [CrossRef]
- Demirel, B.; Taygun, M.E. Antibacterial borosilicate glass and glass ceramics materials doped with ZnO for usage in the pharmaceutical industry. J. ACS Omega 2023, 8, 18735–18742. [Google Scholar] [CrossRef]
- Chen, K.; Wang, F.; Sun, X.; Ge, W.; Zhang, M.; Wang, L.; Zheng, H.; Zheng, S.; Tang, H.; Zhou, Z.; et al. 3D-printed zinc oxide nanoparticles modified barium titanate/hydroxyapatite ultrasound-responsive piezoelectric ceramic composite scaffold for treating infected bone defects. J. Bioactiv. Mater. 2025, 45, 479–495. [Google Scholar] [CrossRef]
- Reinosa, J.J.; Enriquez, E.; Fuertes, V.; Liu, S.; Menenndez, J.; Fernandez, J.F. The challenge of antimicrobial glazed ceramic surfaces. J. Ceram. Inter. 2022, 48, 7393–7404. [Google Scholar] [CrossRef]
- Fadeeva, I.V.; Lazoryak, B.I.; Davidova, G.A.; Murzakhanov, F.F.; Gabbasov, B.F.; Petrakova, N.V.; Fosca, M.; Barinov, S.M.; Vadala, G.; Uskokovic, V.; et al. Antibacterial and cell-friendly copper-substituted tricalcium phosphate ceramics for biomedical implant applications. J. Mater. Sci. Eng. C 2021, 129, 112410. [Google Scholar] [CrossRef] [PubMed]
- Nguyen, N.H.; Lu, Z.; Elbourne, A.; Vasilev, K.; Rooohani, I.; Zreiqat, H.; Truong, V.K. Engineering antibacterial bioceramics: Design principles and mechanisms of action. J. Mater. Today Bio. 2024, 26, 101069. [Google Scholar] [CrossRef] [PubMed]
- Hayek, J.E.; Belaid, H.; Cyr, L.C.S.; Chawich, G.E.; Coy, E.; Iatsunskyi, I.; Gervais, C.; Elango, J.; Ledezma, C.Z.; Bechalany, M.; et al. 3D printed bioactive calcium silicate ceramics as antibacterial scaffolds for hard tissue engineering. J. Mater. Adv. 2024, 5, 3228–3246. [Google Scholar] [CrossRef]
- Vijayakumar, N.; Venkatraman, S.K.; Genasen, K.; Kong, P.; Maria, K.M.N.; Suresh, A.; Abraham, J.; Swamiappan, S. Enhanced bioactivity, antimicrobial efficacy and biocompatibility of silver-doped larnite for orthopedic applications. Arab. J. Chem. 2025, 18, 106055. [Google Scholar] [CrossRef]
- Dagna, A.; Colombo, M.; Poggio, C.; Russo, G.; Pellegrini, M.; Pietrocola, G.; Beltrami, R. In vitro antibacterial activity of different bioceramic root canal sealers. J. Ceram. 2022, 5, 901–907. [Google Scholar] [CrossRef]
- Arias, Z.; Nizami, M.Z.I.; Chen, X.; Chai, X.; Kuang, C.; Omori, K.; Takashiba, S. Recent advances in apical periodontitis treatment: A narrative review. J. Bioengin. 2023, 10, 488. [Google Scholar] [CrossRef]
- Piriz, R.L.; Ball, L.G.; Cabal, B.; Martinez, S.; Moya, J.S.; Bartolome, J.E.; Torrecillas, R. New ceramic multi-unit dental abutments with an antimicrobial glassy coating. J. Mater. 2022, 15, 5422. [Google Scholar] [CrossRef]
- Hazavah, M.R.; Mertowska, P.; Mertowski, S.; Skiba, J.; Krawiec, K.; Łobacz, M.; Grywalska, E. How can imbalance in oral microbiota and immune response lead to dental implants problems? Inter. J. Mol. Sci. 2023, 24, 17620. [Google Scholar] [CrossRef]
- Kamal, M.M.; Mahmud, S.; Plabon, I.A.; Kader, M.A.; Islam, M.N. Effect of sintering temperature on the physical, structural, mechanical and antimicrobial properties of extracted hydroxyapatite ceramics from Anabas testudineus bone and head scull for biomedical applications. J. Res. Mater. 2024, 22, 100590. [Google Scholar] [CrossRef]
- Mirkovic, M.; Filipovic, S.; Kalijadis, A.; Maskovic, P.; Maskovic, J.; Vlahovic, B.; Pavlovic, V. Hydroxyapatite/TiO2 nanomaterial with defined microstructural and good antimicrobial properties. J. Antibiot. 2022, 11, 592. [Google Scholar] [CrossRef] [PubMed]
- Vidal, C.L.; Ferreira, I.; Ferreira, P.S.; Valente, M.L.C.; Teixeira, A.B.V.; Reis, A.C. Incorporation of hybrid nanomaterial in dental porcelains: Antimicrobial, chemical, and mechanical properties. Antibiotics 2021, 10, 98. [Google Scholar] [CrossRef] [PubMed]
- Chen, Z.; Chu, Z.; Jiang, Y.; Xu, L.; Qian, H.; Wang, Y.; Wang, W. Recent advances on nanomaterials for antibacterial treatment of oral diseases. J. Mater. Today Bio. 2023, 20, 100635. [Google Scholar] [CrossRef] [PubMed]
- Fu, R.; Xiao, C.; Zhang, Z.; Ren, K.; Zhou, Z.; Wang, Z.; Ning, C.; Deng, C.; Zhou, L.; Yu, P.; et al. A Nano-CuO doped sodium aluminosilicate composite ceramic with high efficiency against streptococcus mutans for dental restoration materials. J. Ceram. Inter. 2022, 48, 28578–28585. [Google Scholar] [CrossRef]
- Goud, S.V.R.; Singamani, R.; Bhaskar, V.; Kumaran, K.M.; Arafat, M.; Duvvuri, S.N.R. Comparative evaluation of antimicrobial effectiveness of titanium oxide coatings on different types of ceramic brackets against Streptococcus mutans. Inter. Dent. J. Stu. Res. 2022, 10, 60–64. [Google Scholar] [CrossRef]
- Reyna, P.A.S.; Mejia, O.F.O.; Pedroza, M.G.G.; Bastida, N.M.M.; Plata, B.R.; Luckie, R.A.M. Inhibition of the growth of Escherichia coli and Staphylococcus aureus microorganisms in aesthetic orthodontic brackets through the in-situ synthesis of Ag, TiO2 and Ag/TiO2 Nanoparticles. J. Microorg. 2024, 12, 1583. [Google Scholar] [CrossRef]
- El-Hamid, H.K.A.; Fayad, A.M.; Elwan, R.L. Evaluation of bioactivity, biocompatibility, and antibacterial properties of tricalcium silicate bone cement modified with wollastonite/fluorapatite glass and glass-ceramic. J. Ceram. Inter. 2024, 50, 25322–25332. [Google Scholar] [CrossRef]
- Zeidan, N.K.; Enany, N.M.; Mohamed, G.G.; Marzouk, E.S. The antibacterial effect of silver, zinc-oxide and combination of silver/zinc oxide nanoparticles coating of orthodontic brackets (an in vitro study). J. BMC Oral/Health 2022, 22, 230. [Google Scholar] [CrossRef]
- Gudkov, S.V.; Burmistrov, D.E.; Serov, D.A.; Rebezov, M.B.; Semenova, A.A.; Lisitsyn, A.B. Do iron oxide nanoparticles have significant antibacterial properties? Antibiotics 2021, 10, 884. [Google Scholar] [CrossRef]
- Kumar, A.; Mittal, A.; Das, A.; Sen, D.; Mariappan, C.R. Mesoporous electroactive silver doped calcium borosilicate: Structural, antibacterial and myogenic potential relationship of improved bio-ceramics. J. Ceram. Inter. 2021, 47, 3586–3596. [Google Scholar] [CrossRef]
- Pantak, P.; Czechowska, J.P.; Belcarz, A.; Zima, A. The influence of titanium and cooper on physiochemical and antibacterial properties of bioceramic-based composites for orthopedic applications. J. Ceram. Inter. 2025, 51, 1214–1226. [Google Scholar] [CrossRef]
- Marsh, A.C.; Mellott, N.P.; Crimp, M.; Wren, A.; Hammer, N.; Chatzistavrou, X. Ag-doped bioactive glass-ceramic 3D scaffolds: Microstructural, antibacterial, and biological properties. J. Eur. Ceram. Soc. 2021, 41, 3717–3730. [Google Scholar] [CrossRef]
- Yassin, M.T.; Al-Otibi, F.O.; Al-Askar, A.A.; Elmaghrabi, M.M. Synergistic anticandidal effectiveness of greenly synthesized zinc oxide nanoparticles with antifungal agents against nosocomial candida pathogens. J. Microorgan. 2023, 11, 1957. [Google Scholar] [CrossRef]
- Tekin, H.O.; Al-Buriahi, M.S.; Issa, S.A.M.; Zakaly, H.M.H.; Issa, B.; Kebaili, I.; Badawi, A.; Karim, M.K.A.; Matori, K.A.; Zaid, M.H.M. Effect Ag2O substituted in bioactive glasses: A synergistic relationship between antibacterial zone and radiation attenuation properties. J. Mater. Res. Tech. 2021, 13, 2194–2201. [Google Scholar] [CrossRef]
- Baras, B.H.; Melo, M.A.S.; Math, V.T.; Tay, F.R.; Fouad, A.F.; Oates, T.W.; Weir, M.D.; Cheng, L.; Xu, H.H.K. Novel bioactive and therapeutic root canal sealers with antibacterial and remineralization properties. Materials 2020, 13, 1096. [Google Scholar] [CrossRef]
- Jairam, L.S.; Arjun, A.; Premkumar, H.B.; Gali, S.; Deveswaran, R.; Prabhu, T.N. Synthesis, characterization, antibacterial efficacy, and cytotoxicity of monoclinic KMg3(Al0.5B0.5)Si3O10F2: A novel material for anticariogenic applications. J. Ceram. Inter. 2024, 50, 30658–30669. [Google Scholar] [CrossRef]
- Lallukka, M.; Miola, M.; Verne, E.; Baino, F. Silver-doped glass-ceramic scaffolds with antibacterial and bioactive properties for bone substitution. J. Ceram. Inter. 2024, 50, 30997–31005. [Google Scholar] [CrossRef]
- Kumaravel, V.; Nair, K.M.; Mathew, S.; Bartlett, J.; Kennedy, J.E.; Manning, H.G.; Whelan, B.J.; Leyland, N.S.; Pillai, S.C. Antimicrobial TiO2 nanocomposite coatings for surfaces, dental and orthopedic implants. J. Chem. Engin. 2021, 416, 129071. [Google Scholar] [CrossRef]
- Venkatraman, S.K.; Choudhary, R.; Krishnamurithy, G.; Raghavendran, H.R.B.; Murali, M.R.; Kamarul, T.; Suresh, A.; Abraham, J.; Swamiappan, S. Biomineralization, mechanical, antibacterial and biological investigation of larnite and rankinite bioceramics. J. Mater. Sci. Engineer. C 2021, 118, 111466. [Google Scholar] [CrossRef]
- Zhou, H.; Engqvist, H.; Dozel-Gargand, O.; Primetzhofer, D.; Xia, W. N-induced antibacterial capability of ZrO2-SiO2 glass ceramics by ion implantation. J. Appli. Surf. Sci. 2025, 683, 161836. [Google Scholar] [CrossRef]
- Wong, K.W.; Li, Y.J.; Yang, H.C.; Chien, C.S.; Kao, L.T.; Lin, T.S.; Yang, T.Y.; Shih, C.J. Antimicrobial properties of bimetallic-containing mesoporous bioglass against Enterococcus faecalis. J. Dent. Sci. 2025, 20, 510–521. [Google Scholar] [CrossRef] [PubMed]
- Li, C.; Liu, L.; Zhou, Z.; Liu, T.; Zhang, S.; Lu, A. Hydroxyapatite forming ability, ion release and antibacterial activity of the melt-derived SiO2-P2O5-Na2O-Cao-F glasses modified by replacing CaO with SrO and ZnO. J. Ceram. Inter. 2022, 48, 12430–12441. [Google Scholar] [CrossRef]
- Liu, C.; Fu, J.; Li, L.; Wang, H.; Pei, X.; Zhang, T.; Wang, Q. Fabrication of antibacterial and anti-corrosive zirconia ceramics with extreme wettability by facile laser-based surface modification. J. Ceram. Inter. 2024, 50, 22733–22747. [Google Scholar] [CrossRef]
- Negut, I.; Albu, C.; Bita, B. Advances in antimicrobial coating for preventing infections of head-related implantable medical devices. Coatings 2024, 14, 256. [Google Scholar] [CrossRef]
- Xu, J.; Zhang, X.; Dai, J.; Yu, D.; Ji, M.; Chen, M. Biomimetic microtextured surfaces to improve tribological and antibacterial behaviors of 3Y-TZP ceramics. J. Mater. Res. Tech. 2023, 23, 1360–1374. [Google Scholar] [CrossRef]
- Xu, J.; Ji, M.; Li, L.; Wu, Y.; Yu, Q.; Chen, M. Improving wettability, antibacterial and tribological behaviors of zirconia ceramics through surface texturing. J. Ceram. Inter. 2022, 48, 3702–3710. [Google Scholar] [CrossRef]
- Ghalandarzadeh, A.; Ganjali, M.; Hosseini, M. Effect of surface topography through laser texturing on the surface characteristics of zirconia-based dental materials: Surface hydrophobicity, antibacterial behavior, and cellular response. Surf. Topogr. Metrol. Prop. 2023, 11, 025007. [Google Scholar] [CrossRef]
- Sun, X.; Wang, K.; Fan, Z.; Wang, R.; Mei, X.; Lu, Y. Regulation of hydrophobicity on yttria stabilized zirconia surface by femtosecond laser. J. Ceram. Inter. 2021, 47, 9264–9272. [Google Scholar] [CrossRef]
- Moghanian, A.; Zohourfazeli, M.; Tajer, M.H.M. The effect of zirconium content on in vitro bioactivity, biological behavior and antibacterial activity of sol-gel derived 58S bioactive glass. J. Non-Crystal. Solid. 2020, 546, 120262. [Google Scholar] [CrossRef]
- Zhao, R.; Shi, L.; Gu, L.; Qin, X.; Song, Z.; Fan, X.; Zhao, P.; Li, C.; Zheng, H.; Li, Z.; et al. Evaluation of bioactive glass scaffolds incorporating SrO or ZnO for bone repair: In vitro bioactivity and antibacterial activity. J. Appl. Biomater Funct. Mater 2021, 19, 1–12. [Google Scholar] [CrossRef]
- Bian, S.; Li, G.; Cheng, S.; Wang, D.; Cao, J.; Qi, T. Stable and active sites fully exposed antibacterial ceramics obtained from Ce-based glass-ceramics via the method of facile in-situ etching. J. Alloys Compon. 2025, 1010, 177130. [Google Scholar] [CrossRef]
- Li, P.; Dai, J.; Li, Y.; Alexander, D.; Capek, J.; Gerstorfer, J.G.; Wan, G.; Han, J.; Yu, Z. Zinc based biodegradable metals for bone repair and regeneration: Bioactivity and molecular mechanisms. J. Mater. Today Bio. 2024, 25, 100932. [Google Scholar] [CrossRef]
- Gavinho, S.R.; Padua, A.S.; Nogueira, I.S.; Silva, J.C.; Borges, J.P.; Costa, L.C.; Graca, M.P.F. Biocompatibility, bioactivity and antibacterial behaviour of cerium-containing bioglass. J. Nanomater. 2022, 12, 4479. [Google Scholar] [CrossRef]
- Jairam, L.S.; Shri, D.; Chandrashekar, A.; Prabhu, T.; Arjun, A.; Premkumar, H.B. Antibacterial and mechanical properties of cerium oxide nanoparticles modified glass ionomer cement. J. Mater. Chem. Phys. 2024, 315, 129040. [Google Scholar] [CrossRef]
- Jiang, Y.; Zhang, C.; Xu, J.; Xu, J.; Zhan, X.Q.; Ma, N.; Tsai, F.C. An overview of dental-glass-ceramics: From material design to the manufacturing process. Int. J. Ceram. Eng. Sci. 2024, 6, e10224. [Google Scholar] [CrossRef]
- Kongkiatkamon, S.; Rokaya, D.; Kengtanyakich, S.; Peampring, C. Current classification of zirconia in dentistry: An updated review. PeerJ 2023, 11, e15669. [Google Scholar] [CrossRef]
- Gomes, P.L.; Freitas, B.X.; Alves, M.F.R.P.; Olhero, S.; Santos, K.F.; Davila, J.L.; Daguano, J.K.M.B.; dos Santos, C. Development of zirconia based ceramics stabilized with different yttria contents shaped by extrusion 3D-printing. J. Mater. Res. Technol. 2024, 28, 2909–2923. [Google Scholar] [CrossRef]
- Makvandi, P.; Wang, C.Y.; Zare, E.N.; Borzacchiello, A.; Niu, L.N.; Tay, F.R. Metal-based nanomaterials in biomedical applications: Antimicrobial activity and cytotoxicity aspects. J. Adv. Funct. Mater. 2020, 30, 1910021. [Google Scholar] [CrossRef]
- Lopez, E.S.; Gomes, D.; Esteruelas, G.; Bonilla, L.; Machado, A.L.L.; Galindo, R.; Cano, A.; Espina, M.; Ettcheto, M.; Camins, A.; et al. Metal-based nanoparticles as antimicrobial agents: An overview. J. Nanomater. 2020, 10, 292. [Google Scholar] [CrossRef]
- Paryab, A.; Godary, T.; Khalilifard, R.; Khachatourin, A.M.; Abdollahi, F.; Abdollahi, S. The effect of Ag incorporation on the characteristics of the polymer derived bioactive silicate phosphate glass-ceramic scaffolds. Ceram. Y Vidrio 2022, 61, 653–662. [Google Scholar] [CrossRef]
- Henderson, C.M.B. Composition, thermal expansion and phase transitions in framework silicates: Revisitation and review of natural and synthetic analogues of nepheline-, feldspar- and leucite-mineral groups. J. Solids 2020, 2, 1–49. [Google Scholar] [CrossRef]
- Uehara, L.M.; Ferreira, I.; Botelho, A.L.; Valente, M.L.C.; Reis, C.A. Influence of ß-AgVO3 nanomaterial incorporation on mechanical and microbiological properties of dental porcelain. J. Dent. Mater. 2022, 38, E174–E180. [Google Scholar] [CrossRef] [PubMed]
- Singh, S.; Gurjar, A.; Bhatia, E.; Pareek, S.; Krishnatrey, I.; Awasthi, L.; Dani, P.; Srivastava, R.; Kapoor, S.; Bhargava, P. Tailoring antimicrobial characteristic and mechanical behavior with silver in leucite-glass-ceramics for hard tissue engineering. Int. J. Appl. Ceram. Technol. 2024, 21, 2081–2093. [Google Scholar] [CrossRef]
- Bisht, N.; Dwivedi, N.; Kumar, P.; Venkatesh, M.; Yadav, A.K.; Mishra, D.; Solanki, P.; Verma, N.K.; Lakshminarayanan, R.; Ramakrishna, S.; et al. Recent advances in copper and copper-derived materials for antimicrobial resistance and infection control. J. Curr. Opin. Biomed. Eng. 2022, 24, 100408. [Google Scholar] [CrossRef]
- D’Onofrio, A.; Hill, R.G.; Kent, N.V.; Rawlinson, S.C.F.; Shahdad, S.A. Development of novel formulation of bioactive glass-based calcium phosphate cement for bone grafting. J. Adv. Funct. Mater. 2024, 34, 2401953. [Google Scholar] [CrossRef]
- Christie, B.; Musri, N.; Djustiana, N.; Takarini, V.; Tuygunov, N.; Zakaria, M.N.; Cahyanto, A. Advances and challenges in regenerative dentistry: A systematic review of calcium phosphate and silicate-based materials on human dental pulp stem cells. J. Mater. Today Bio. 2023, 23, 100815. [Google Scholar] [CrossRef]
- Fatimah, I.; Hidayat, H.; Citradewi, P.W.; Tamyiz, M.; Doong, R.; Sagadevan, S. Hydrothermally synthesized titanium/hydroxyapatite as photoactive and antibacterial biomaterial. Helion 2023, 9, e14434. [Google Scholar] [CrossRef]
- Hallmann, L.; Gerngroß, M.-D. Chitosan and its application in dental implantology. J. Stomatol. Oral Maxillofac Surg. 2022, 123, e701–e707. [Google Scholar] [CrossRef]
- O’Connor, J.P.; Kanjilai, D.; Teitelbaum, M.; Lin, S.S.; Cottrell, J.A. Zinc as a therapeutic agent in bone regeneration. Materials 2020, 13, 2211. [Google Scholar] [CrossRef]
- Kiouri, D.P.; Tsoupra, E.; Peana, M.; Perlepes, S.P.; Stefanidou, M.E.; Chasapis, C.T. Multifunctional role of zinc in human health: An update. J. EXCLI 2023, 22, 809–827. [Google Scholar]
- Molenda, M.; Kolmas, J. The role of zinc in bone tissue health and regeneration—A review. J. Bio. Trace Elem. Res. 2023, 201, 5640–5651. [Google Scholar] [CrossRef]
- Fernandes, M.H.; Alves, M.M.; Cebotarenco, M.; Ribeiro, I.A.C.; Grenho, L.; Gomes, P.S.; Carmezim, M.J.; Santos, C.F. Citrate zinc hydroxyapatite nanorods with enhanced cytocompatibility and osteogenesis for bone regeneration. J. Mater. Sci. Engin. C 2020, 115, 111147. [Google Scholar] [CrossRef] [PubMed]
- Xia, P.; Lian, S.; Wu, Y.; Yan, L.; Quan, G.; Zhu, G. Zinc is an important inter-kingdom signal between the host and microbe. J. Vet. Res. 2021, 52, 39. [Google Scholar] [CrossRef]
- Wang, Z.; Wang, X.; Wang, Y.; Zhu, Y.; Liu, X.; Zhou, Q. Nano ZnO-modified titanium implants for enhanced anti-bacterial activity, osteogenesis and corrosion resistance. J. Nanobiotechnol. 2021, 19, 353. [Google Scholar] [CrossRef] [PubMed]
- Esposti, L.D.; Ionescu, A.C.; Carella, F.; Adamiano, A.; Brambilla, E.; Iafisco, M. Antimicrobial activity of remineralizing ion-doped amorphous calcium phosphates for preventive dentistry. J. Front. Mater. 2022, 9, 846130. [Google Scholar] [CrossRef]
- Sheng, X.; Li, C.; Wang, Z.; Xu, Y.; Sun, Y.; Zhang, W.; Liu, H.; Wang, J. Advanced applications of strontium-containing biomaterials in bone tissue engineering. J. Mater. Today Bio. 2023, 20, 100636. [Google Scholar] [CrossRef]
- Ghezzi, D.; Graziani, G.; Cappelleti, M.; Fadeeva, I.V.; Montesissa, M.; Sassoni, E.; Borciani, G.; Barbaro, K.; Boi, M.; Baldini, N.; et al. New strontium-based coatings show activity against pathogenic bacteria in spine infection. J. Front. Bioeng. Biotechnol. 2024, 12, 1347811. [Google Scholar] [CrossRef]
- Abdalla, M.M.; Sayed, O.; Lung, C.Y.K.; Rajasekar, V.; Yiu, C.K.Y. Applications of bioactive strontium compounds in dentistry. J. Funct. Biomater. 2024, 15, 216. [Google Scholar] [CrossRef]
- Pham, D.Q.; Gangadoo, S.; Lu, Z.; Berndt, C.C.; Newsom, E.T.; Zreiqat, H.; Truong, V.K.; Ang, A.S.M. Strontium-doped hardystonite plasma sprayed coating with robust antimicrobial activity. J. Mater. Today Chem. 2022, 24, 100822. [Google Scholar] [CrossRef]
- Alshammari, H.; Neilands, J.; Svensäter, G.; Stavropoulos, A. Antimicrobial potential of strontium hydroxide on bacteria associated with peri-implantitis. Antibiotics 2021, 10, 150. [Google Scholar] [CrossRef]
- Kajimoto, N.C.; Buischi, Y.P.; Mohamadzadeh, M.; Loomer, P. The oral microbiome of peri-implant health and disease: A narrative review. J. Dent. 2024, 12, 299. [Google Scholar] [CrossRef]
- Chen, X.; Zhou, J.; Qian, Y.; Zhao, L.Z. Antibacterial coating on orthopedic implants. J. Mater. Today Bio. 2023, 19, 100586. [Google Scholar] [CrossRef] [PubMed]
- Han, M.; Dong, Z.; Li, J.; Luo, J.; Yin, D.; Sun, L.; Tao, S.; Zhen, L.; Yang, J.; Li, J. Mussel-inspired self-assembly engineered implant coatings for synergistic anti-infection and osteogenesis acceleration. J. Mater. Chem. B 2021, 40, 8501–8511. [Google Scholar] [CrossRef] [PubMed]
- Go, H.B.; Lee, M.J.; Seo, J.Y.; Byun, S.Y.; Kwon, J.S. Mechanical properties, sustainable bacterial resistance effect of strontium-modified phosphate-based glass microfiller in dental composite resins. J. Sci. Rep. 2023, 13, 17763. [Google Scholar] [CrossRef] [PubMed]
- Dai, L.L.; Mei, M.L.; Chu, C.H.; Lo, E.C.M. Effect of strontium-doped bioactive glass-ceramic containing toothpaste on prevention of artificial dentine caries formation: An in vitro study. J. BMC Oral Health 2022, 22, 288. [Google Scholar] [CrossRef]
- Zhang, Y.; Zheng, J. Bioinformatics of metalloproteins and metalloproteomes. Molecules 2020, 25, 3366. [Google Scholar] [CrossRef]
- Comisso, I.; Herrera, S.A.; Gupta, S. Zirconium dioxide implants as an alternative to titanium; a systematic review. J. Clin. Exp. Dent. 2021, 13, e511-9. [Google Scholar] [CrossRef]
- Hammami, I.; Gavinho, S.R.; Padua, A.S.; Sa-Nogueira, I.; Silva, J.C.; Borges, J.P.; Valente, M.A.; Graça, M.P.F. Bioactive glass modified with zirconium incorporation for dental implant applications: Fabrication, structural electrical, and biological analysis. Inter. J. Mol. Sci. 2023, 24, 10571. [Google Scholar] [CrossRef]
- Zheng, S.; Bawazir, M.; Dhall, A.; Kim, H.E.; Heo, J.; Hwang, G. Implication of surface properties, bacterial motility, and hydrodynamic conditions on bacterial surface sensing and their initial adhesion. J. Front. Bioengi. Biotechnol. 2021, 9, 643722. [Google Scholar] [CrossRef]
- Krsmanovic, M.; Biswas, D.; Ali, H.; Kumar, A.; Ghosh, R.; Dickerson, A.K. Hydrodynamics and surface properties influence biofilm proliferation. Adv. Colloid Interface Sci. 2021, 288, 102336. [Google Scholar] [CrossRef]
- Yu, C.; Sasic, S.; Liu, K.; Salameh, S.; Ras, R.H.A.; Ommen, J.R. Nature-inspired self-cleaning surfaces: Mechanisms, modelling, and manufacturing. J. Chem. Engin. Res. Desig. 2020, 155, 48–65. [Google Scholar] [CrossRef]
- Fernandes, B.F.; Silva, N.; Cruz, M.B.D.; Garret, G.; Carvalho, O.; Silva, F.; Mata, A.; Francisco, H.; Marques, J.F. Cell biological and antibacterial evaluation of a new approach to zirconia implant surfaces modified with MTA. Biomimetics 2024, 9, 155. [Google Scholar] [CrossRef] [PubMed]
- Kiribayashi, R.; Nakane, R.; Sunada, K.; Mochizuki, Y.; Isobe, T.; Nagai, T.; Ishiguro, H.; Nakajima, A. Antiviral and antibacterial activities of yttria-stabilized zirconia. J. Mater. Lett. 2024, 367, 136658. [Google Scholar] [CrossRef]
- Paun, A.G.; Dumitriu, C.; Ungureanu, C.; Popescu, S. Silk fibroin/ZnO coated TiO2 nanotubes for improved antimicrobial effect of Ti dental implants. Materials 2023, 16, 5855. [Google Scholar] [CrossRef]
- Tang, J.; Wie, F.; Zhao, L.; Yang, L.; Li, J.; Sun, Z.; Yang, C.; Zhang, W.; Liu, B. Superior antibacterial properties of copper-doped titanium oxide films prepared by micro-arc oxidation. J. Ceram Inter. 2024, 50, 1370–1378. [Google Scholar] [CrossRef]
- Chatzimentor, I.; Tsamesidis, I.; Ioannou, M.E.; Pouroutzidou, G.K.; Beketova, A.; Giourieva, V.; Papi, R.; Kontonasaki, E. Study of biological behavior and antimicrobial of cerium oxide nanoparticles. Pharmaceutics 2023, 15, 2509. [Google Scholar] [CrossRef]
- Wang, Y.; Zhang, X.; Zheng, H.; Zhou, Z.; Li, S.; Jiang, J.; Li, M.; Fu, B. Remineralization of dentin with cerium oxide and its potential use for root canal disinfection. Inter. J. Nanomed. 2024, 19, 1–17. [Google Scholar] [CrossRef]
- Gour, S.; Mukherjee, A.; Balani, K.; Dhami, N.K. Atomic force microscopic investigations of transient early-stage bacterial adhesion and antibacterial activity of silver and ceria modified bioactive glass. J. Mater. Res. 2024, 39, 2415–2430. [Google Scholar] [CrossRef]
- Byun, S.Y.; Han, A.R.; Kim, K.M.; Kwon, J.S. Antibacterial properties of mesoporous silica coated with cerium oxide nanoparticles in dental resin composite. J. Sci. Rep. 2024, 14, 18014. [Google Scholar] [CrossRef]
- Zheng, H.; Tang, J.; Wei, Y.; Deng, X.; Zhang, Y.; Ma, X.; Jiang, X.; Xu, Z.P.; Liao, H. Antibacterial properties of cerium nanoparticles: Recent progresses and future challenges. Particuology 2024, 93, 264–283. [Google Scholar] [CrossRef]
- Varghese, E.J.; Sihivahanan, D.; Vankatesh, V.V. Development of a novel antimicrobial dental composite resin with nano cerium oxide fillers. Inter. J. Biomater. 2022, 2022, 3912290. [Google Scholar] [CrossRef] [PubMed]

| Materials | Crystalline Microstructure | Manufacturing Technique | Mechanical Properties | Clinical Applications | Ref. |
|---|---|---|---|---|---|
| Glass-ceramics | |||||
| Lithium disilicate (Li2Si2O3) | Morphology: needle-like crystals (~70 vol%) length 3–6 µm | Hot press (CAD/CAM) | σ: 350–450 MPa Hv: 4–6.5 GPa KIc: 0.8–1.5 MPa m1/2 E: ~70 GPa CTE: 10.2 ± 0.4 × 10−6 K−1 (100–400 °C), 10.6 ± 0.35 × 10−6 K−1 (100–500 °C) | Crowns, bridges in the anterior regions up to premolars, resin-bonded veneers, inlays, onlays | [5,66] |
| Zirconia-reinforced lithium silicate (Vita Suprinity®PC) | Morphology: homogeneous fine Li2SiO3 crystals ZrO2 particles (~70 wt%) | CAD/CAM | σ: 444 ± 39 MPa Hv: 6.5 ± 0.5 GPa KIc: 2.31 ± 0.17 MPa∙m1/2 E: 70 ± 2 GPa | Crowns in the anterior and posterior regions, inlays, onlays, single-tooth restorations on implant abutments | [5,66] |
| Leucite -based (K2O.Al2O3.4SiO2) | Morphology: lamina-like crystals (30–50 wt%) size: 1–4 µm | Hot press CAD/CAM | σ: 80–120 MPa Hv: ∼6.5 GPa KIc: 0.7−1.2 MPa∙m1/2 E: ~70 GPa CTE: 16.6 × 10−6 K−1 (100–400 °C) 17.5 × 10−6 K−1 (100–500 °C) | Crowns, veneers, inlays, onlays, resin-bonded laminates | [5,66] |
| Bioceramics | |||||
| Zpex (3Y-TZP, 3 mol% Y2O3) | Morphology: ZrO2 particles size: ~0.40–0.43 µm | CAD/CAM | σ: 1100 MPa Hv: 1023 ± 90 KIc: 5.45 ± 0.9 MPa1/2 CTE: 10.8 × 10−6 K−1 | Custom abutments on titanium bases, crowns and 4-unit to multi-unit bridge frameworks, multi-unit screw-retained restorations on titanium bases | [67,68] |
| Zpex 4 (4Y-PSZ, 4 mol% Y2O3) | Morphology: ZrO2 particles size: ~0.46 µm | CAD/CAM | σ: >900 MPa Hv: 921 ± 77 KIc: 4.32 ± 0.6 MPa1/2 CTE: 10.8 × 10−6 K−1 | Crowns and 4- to multi-unit bridges, multi-unit screw-retained constructions on Ti bases | [67,68] |
| Zpex-Smile (5Y-PSZ, 5 mol% Y2O3) | Morphology: ZrO2 particles size: ~0.53 µm | CAD/CAM | σ: 900–1100 MPa Hv: 896.0 ± 65 KIc: 4.15 ± 0.5 MPa1/2 CTE: 10.2 × 10−6 K−1 | Crowns and bridges (<3 units extending to the molar region), veneers, inlays, onlays | [67,68] |
Disclaimer/Publisher’s Note: The statements, opinions and data contained in all publications are solely those of the individual author(s) and contributor(s) and not of MDPI and/or the editor(s). MDPI and/or the editor(s) disclaim responsibility for any injury to people or property resulting from any ideas, methods, instructions or products referred to in the content. |
© 2025 by the authors. Licensee MDPI, Basel, Switzerland. This article is an open access article distributed under the terms and conditions of the Creative Commons Attribution (CC BY) license (https://creativecommons.org/licenses/by/4.0/).
Share and Cite
Hallmann, L.; Gerngross, M.-D. Antibacterial Ceramics for Dental Applications. Appl. Sci. 2025, 15, 4553. https://doi.org/10.3390/app15084553
Hallmann L, Gerngross M-D. Antibacterial Ceramics for Dental Applications. Applied Sciences. 2025; 15(8):4553. https://doi.org/10.3390/app15084553
Chicago/Turabian StyleHallmann, Lubica, and Mark-Daniel Gerngross. 2025. "Antibacterial Ceramics for Dental Applications" Applied Sciences 15, no. 8: 4553. https://doi.org/10.3390/app15084553
APA StyleHallmann, L., & Gerngross, M.-D. (2025). Antibacterial Ceramics for Dental Applications. Applied Sciences, 15(8), 4553. https://doi.org/10.3390/app15084553





